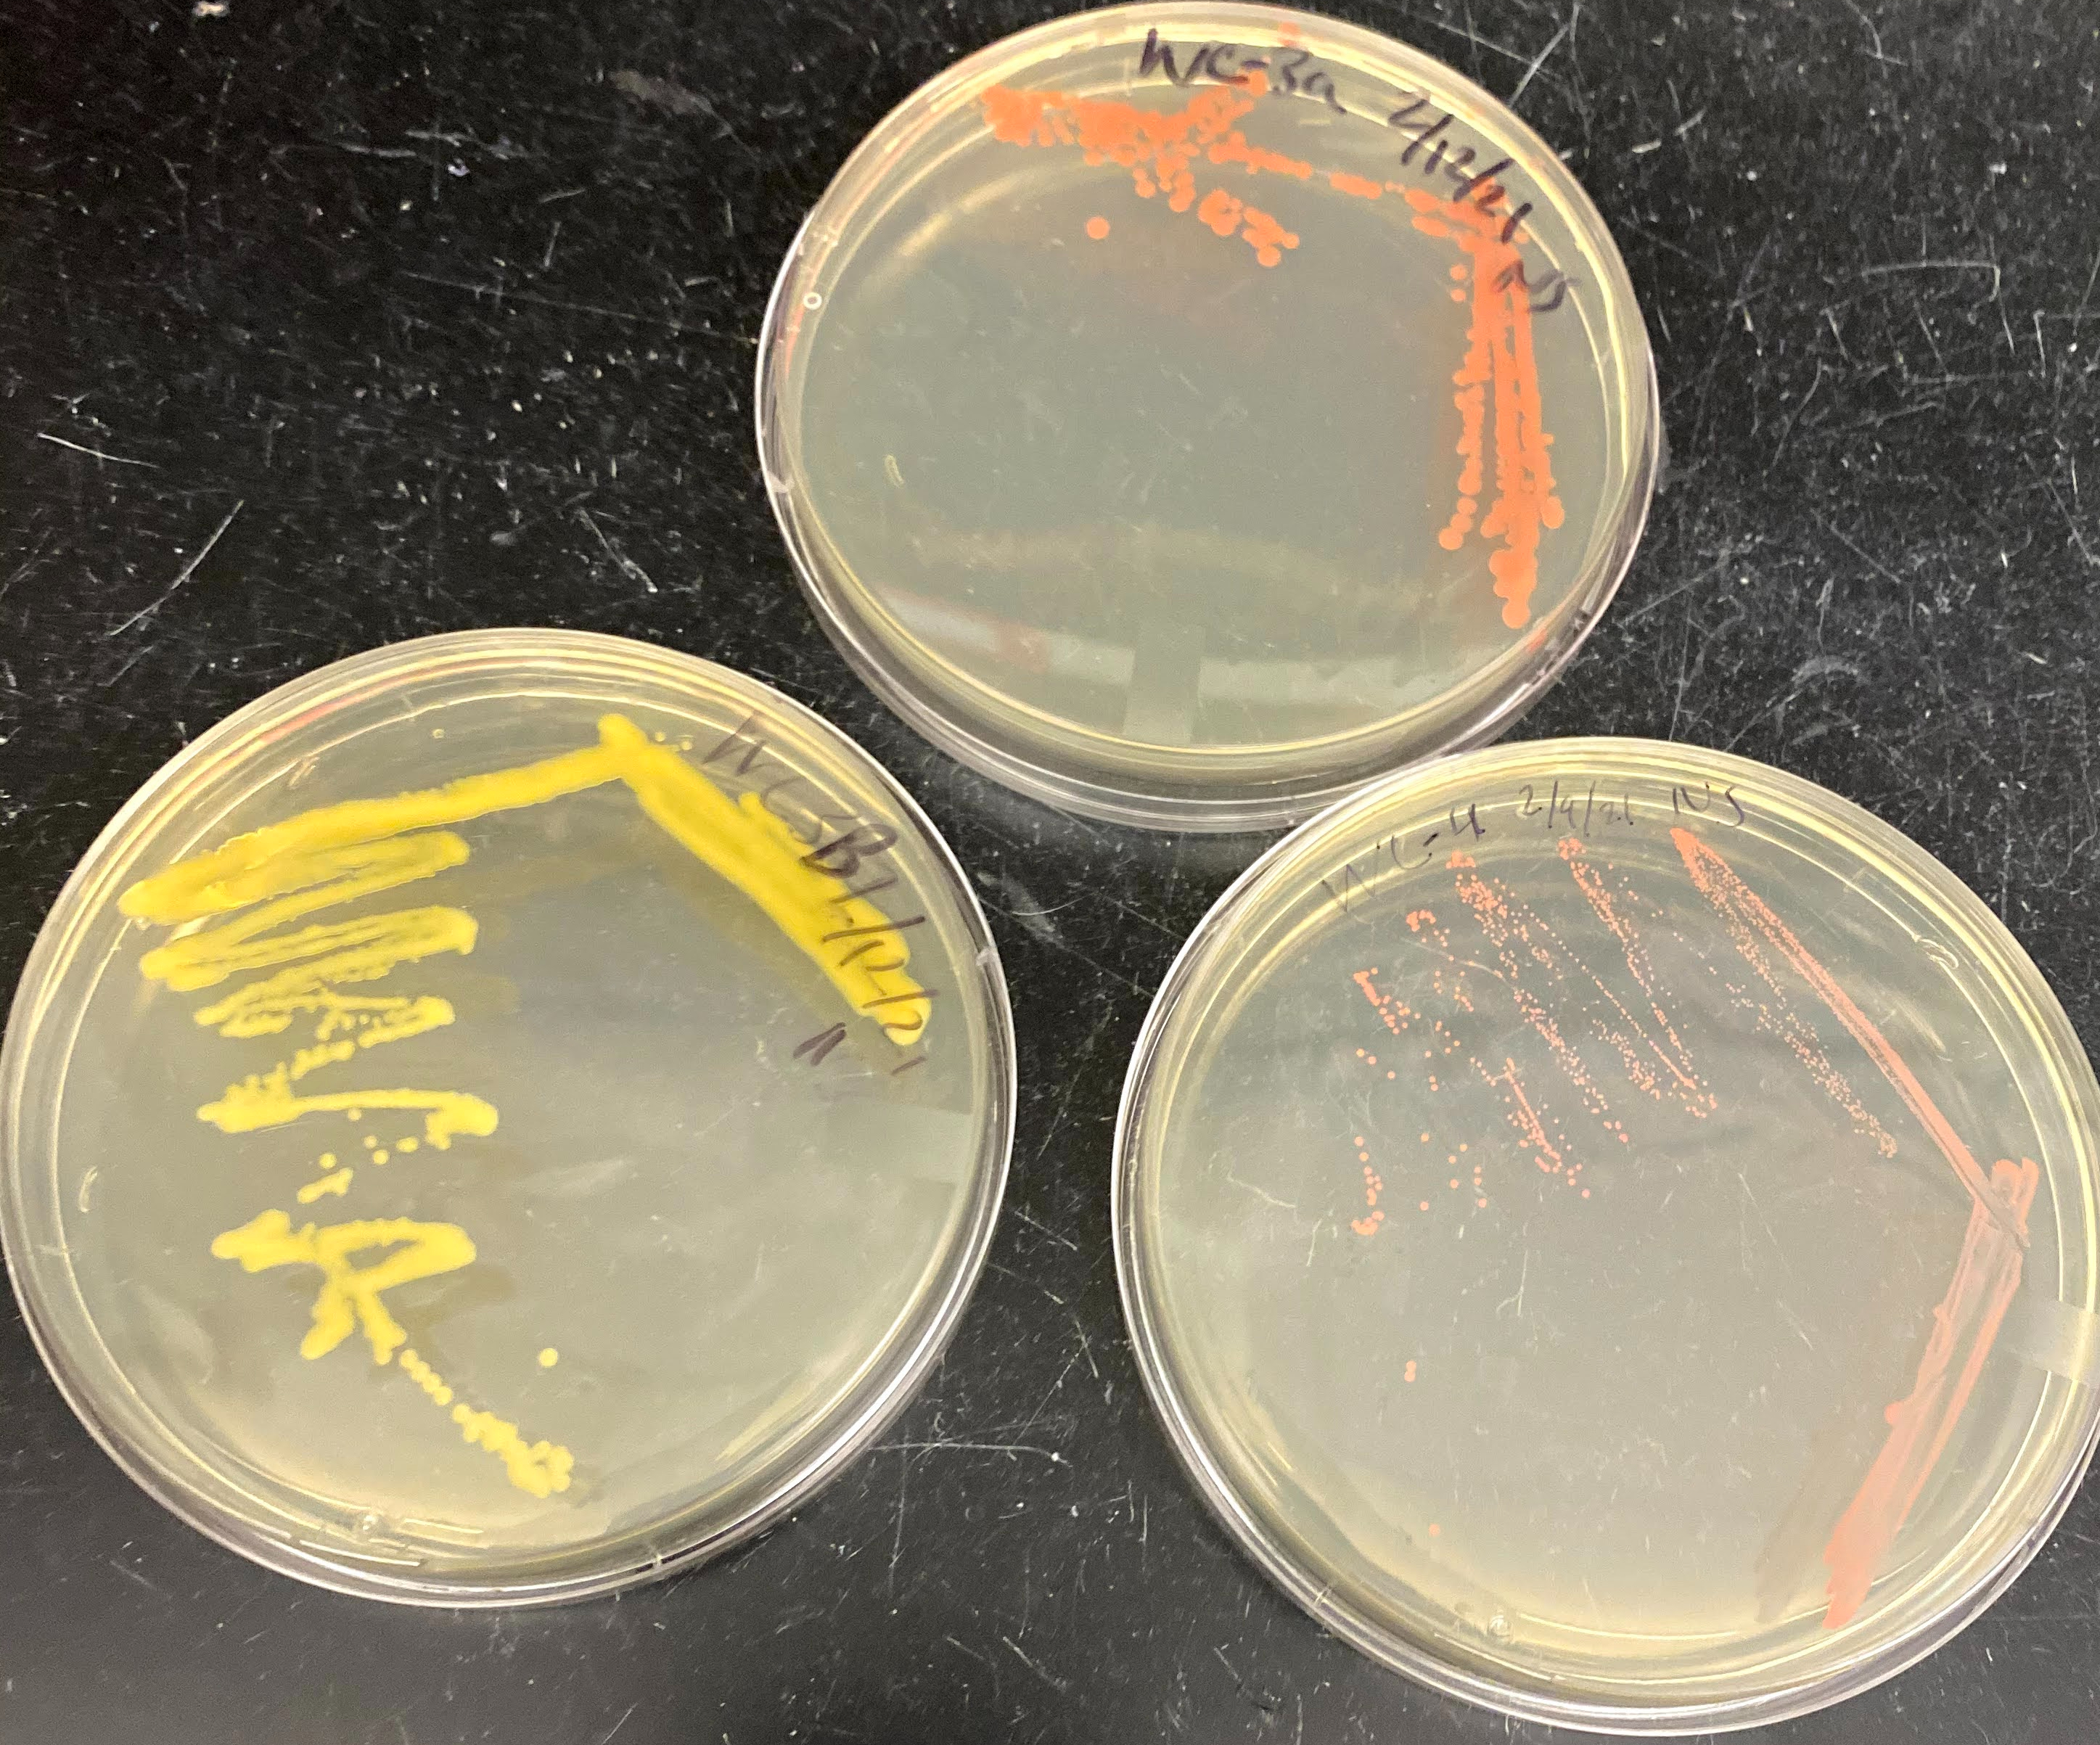

Engineering microbial communities to survive the fecal sludge environment and accelerate decomposition
Microbes are everywhere: our stomachs, the soil, and extreme environments. They are able to colonize different ecosystems because they evolve rapidly and have a broad range of metabolisms. We aim to harness the power of these tiny organisms accelerate composting of fecal sludge in non-sewered toilets.
Typically, urine kills the beneficial microbes in fecal sludge and decomposition stops. At Humus, our product is the perfect blend of microbes that can metabolize the urine in safe concentrations and allow the microbes to start composting. The high temperature reached will kill the pathogenic microbes and the composting process will reduce the volume of the fecal sludge.